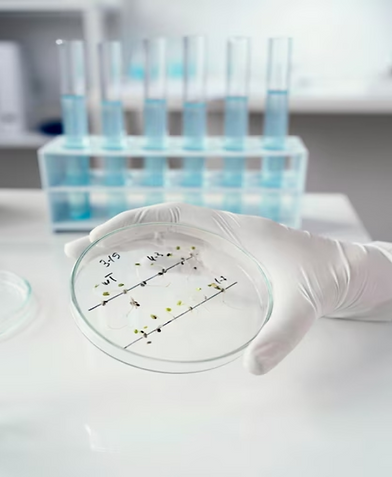

top of page
¡Échale un vistazo a nuestro Blog!
Reflexiones y Tips Contenidos técnicos nuevos cada semana.
Explora el BLOG de HW para descubrir artículos y consejos interesantes sobre las últimas tendencias en el mundo del laboratorio y de la filtración de laboratorio. Mantente informado y al día con nuestras promociones y ofertas exclusivas.
bottom of page

















